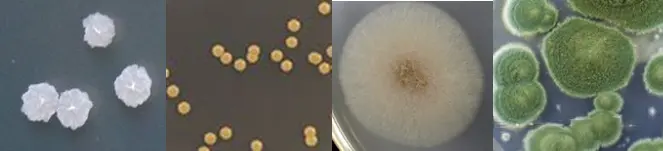
微生物群体形态特征

微生物分类鉴定的方法
发布时间:2025-03-07 浏览次数:1791
微生物的分类是为了把各种微生物按照亲缘关系分门别类,方便人们对微生物进行鉴定和交流;而微生物鉴定是为了将未知的菌株按照其生物学特性进行分类或者说归类,微生物分类采用的是鉴定的方法,微生物鉴定后又需要按照分类规则归类,二者相辅相成,密不可分。
曾经从朋友那里获得一株枯草芽孢杆菌,经过三个月的试验,活菌数一直达不到枯草芽孢杆菌的平均水平,一度怀疑是不是做的有问题或原料有问题亦或是人员操作不当,经过排查,菌种并非枯草芽孢杆菌,实验过程中为什么没有发现?因为同一个属相近的种之间很类似,很多时候没法用肉眼进行辨别,引用伯杰细菌鉴定手册中给种的定义,凡是与典型培养菌非常相同的其他培养菌统一起来。乌龙事件常有,但希望不是你。所以,做好菌种分类鉴定相当重要。
继续巩固一下前面的知识,
分类是根据微生物的相似性和亲缘关系,将微生物归入不同的类群(分类单元);
命名是根据国际生物命名法规给微生物分类单元以科学的名称;
鉴定是将确定一个新的分类微生物属于已经命名的分类单元的过程;
培养物是指一定时间一定空间内微生物的细胞群或生长物。
微生物分类鉴定的方法
一、传统鉴定法
传统鉴定方法主要通过微生物细胞的形态和生理生化习性进行鉴定。
要想鉴定,我们首先要获得该微生物的纯培养物,这一点非常重要。只有纯培养物才能进行鉴定,不管是传统鉴定方法还是现代鉴定方法,无一例外。
1 形态学特征
形态学特征分为个体形态学特征和群体形态学特征。
个体形态学特征主要借助显微镜进行观察分析,比如说,细菌细胞的大小(测微尺,主要测量直径),形状(杆菌、球菌还是螺旋型),排列方式(单个、八字型还是连状),有无鞭毛,有无荚膜,芽孢的位置(侧面、中间还是一端),革兰氏染色阳性还是阴性。

群体形态特征主要通过观察微生物生长状态,比如说,在固体培养基上菌落的形态(表面是否光滑、颜色、边缘是否圆滑,中间和边缘是否一致、正面和反面是否一致,有无突起等),在液体培养基中的生长情况(有无菌膜、味道)。
在平时的实验研究中,主要以形态特性为主进行菌种鉴定,既方便又实用。基本上分离出纯培养物,鉴定也结束了。进行菌种形态描述,拍照留存,还有最重要的一环-保藏菌种,后续详细说明。
2 生理生化特征
微生物中涉及到生理生化实验共有12个:糖酵解,淀粉水解试验,V-P试验,甲基红试验,靛基质试验,硝酸盐还原试验,明胶液化试验,尿素酶试验,氧化酶试验,硫化氢试验,三糖铁琼脂试验,硫化氢-靛基质-动力琼脂试验。
3 生态学特性
主要包括:生长温度(最适、最低和最高温度),pH值,水分,渗透压(是否耐高渗,是否有嗜盐性等)的适应性,需氧性(好氧、微好氧、厌氧及兼性厌氧),宿主的种类及其与宿主的关系(共生、互生、寄生)。
4 血清学反应(又称抗原抗体反应)
优点:特异性强、灵敏度高、简便快速。
在微生物分类鉴定中,常用已知菌种、型或菌株制成抗血清(抗体),根据它是否与待鉴定的对象发生特异性结合反应来鉴定未知菌种、型或菌株(抗原)。
常用血清学试验:凝集反应、沉淀反应、补体结合反应、免疫荧光抗体技术、酶联免疫吸附试验、免疫组织化学等方法。
5 微生物的微型、简便、快速或自动化鉴定技术
经典鉴定方法指标明确,形态学特征观察比较简单,生理生化试验就没那么容易,毕竟需要一个一个试验,但要想鉴定某个菌种是哪个种,需要花费大量的时间和精力,尤其对于生长慢的的菌种。
微生物微型、简便、快速或自动化鉴定技术的出现,正好弥补了上述的不足,要不说,科技在发展,效率必须跟上。
(1)、API细菌数值检定系统:可以同时检测15个以上生化指标,快速、准确、简便和经济,广泛应用于医疗卫生、食品加工和环境监测等领域。

(2)、“Enterotube”系统:由于鉴定项目有限,只适合于一些肠道细菌的鉴定,但准确度高。

(3)、“Biolog”全自动和手动细菌鉴定系统:自动化、快速、高效和应用范围广。此系统适用于动、植物检疫,临床和兽医的检验,食品、饮水卫生的监控,药物生产,环境保护,发酵过程控制,生物工程研究,以及土壤学、生态学和其他研究工作等。

(4)、细菌和病毒的灵敏快速鉴定法
生物芯片法:提取DNA,PDR扩增,鉴定
免疫传感器法;
激光散射仪法。
6 数值分类法
该方法是利用现代手段进行表型特性鉴定的方法。需要的指标较多,但结果也算稳定和客观。
尽管自动化技术弥补了一部分经典方法的缺点,还有一个缺点就是不够客观,不能很准确的鉴定菌种,容易犯经验主义错误。随着现代鉴定技术的革新,以表型特征进行鉴定的经典鉴定方法逐渐边缘化,成为辅助性的鉴定方法。
二、核算鉴定法
1 DNA的碱基组成(G+C)mol%
(G+C)mol%,也叫GC比,目前发表任何微生物新种时所必须具有的重要指标,即

(1)亲缘关系相近的种,其基因组的核苷酸序列相近,两者的GC比也接近;
(2)GC比差距很大的两种微生物,它们的亲缘关系必然较远;
(3)GC比是建立新分类单元时的可靠指标。
据测定,GC比相差低于2%时,没有分类学上的意义;种内各菌株间的差别在2.5%~4.0%间;若相差在5%以上时,就可认为属于不同的种了;假如差距超过10%,一般就可以认为是不同的属了。
2 核酸的分子杂交

3 rRNA寡核苷酸编目分析
一种通过分析原核或真核细胞中最稳定的rRNA寡核苷酸序列同源性程度,以确定不同生物间的亲缘关系和进化谱系的方法。
原核生物:16SrRNA
真核生物:18SrRNA
对于真核微生物物种鉴定,基于测序的方法,常选择18SrDNA + ITS区域作为基因组的靶区域进行序列数据获取和分析,从而得到更精准的物种分类信息。
特点:核苷酸数适中,信息量大,易于分析。
RNA作为进化的指征的优点:
- rRNA具有重要且恒定的生理功能;
- 在16SrRNA分子中,既含有高度保守的序列区域,又有中度保守和高度变化的序列区域,因而它适用于进化距离不同的各类生物亲缘关系的研究;
- 16SrRNA分子量大小适中,便于序列分析;
- rRNA在细胞中含量大(约占细胞中RNA的90%),也易于提取;
- 16SrRNA普遍存在于真核生物和原核生物中(真核生物中其同源分子是18SrRNA)。因此它可以作为测量各类生物进化的工具。

4 微生物全基因组序列的测定
对菌落进行全基因组测序是菌种鉴定的终极解决方案,可以直接鉴定到菌株。相较rRNA核酸序列检测更要准确。
三、成分鉴定法
1 细胞壁的化学成份:原核生物细胞壁成分的分析,对菌种鉴定有一定的作用。
2 磷酸类脂成分的分析:位于细菌、放线菌细胞膜上的磷酸类脂成分,在不同属中有所不同,可用作鉴别属的指标。
3 气相色谱技术用于微生物鉴定:气相色谱技术主要分析微生物细胞和代谢产物中的脂肪酸和醇类等成分,进而对菌种进行分类,尤其对厌氧菌等的鉴定十分有用。

文章来源:环凯转载于“ 微生物知识库”公众号;原标题:“微生物分类鉴定的方法”;作者~发酵菌人。
转载声明:本文为转载发布,仅为分享学习目的。对转载有异议和删稿要求的原著方,可联络站点客服删除。






